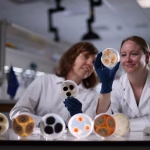

Иран наводно егзекутирал врвен израелски шпион
Иран егзекутирал човек за кој рекол дека е еден од врвните израелски шпиони во земјата.
Иран егзекутирал осомничен израелски шпион по втор пат овој месец. „Еден од врвните шпиони на ционистичкиот режим во Иран, Бахман Шуби Асл, беше обесен утрово“, објави Мизан Онлајн.
Егзекутираниот човек, чиј датум на апсење е нејасен, наводно имал „привилегиран пристап“ до клучните ирански бази на податоци и се вели дека тесно соработувал со израелската разузнавачка служба.
Последниот пат кога иранските власти егзекутирале човек за наводно шпионирање за Израел бил пред нешто повеќе од една недела.
Според норвешката невладина организација Иран човекови права (IHR), најмалку илјада луѓе се егзекутирани во Исламската република оваа година, од кои најмалку 64 во изминатата недела.
-
Latest news
Tags
Џо Бајден Владимир Путин Володимир Зеленски Извадок на дел од дневните настани Илон Маск Ковачевски. Пендаровски ТА Турист Битола Туристичка Агенција - Турист Битола бајден војна германија доналд трамп земјотрес киев кина нато новак ѓоковиќ одземеното вратено на сопственикот османи приведен дилер приведено едно лице пронајдена дрога северна кореја сончево турција
ЗА НАС
ОhridSky е ваш доверлив извор за сеопфатно и избалансирано покривање на вестите. Со посветеност на интегритет и точност, обезбедуваме длабинско известување кое ги открива приказните што се најважни.
Links

© 2025 OhridSky. Сите права задржани.